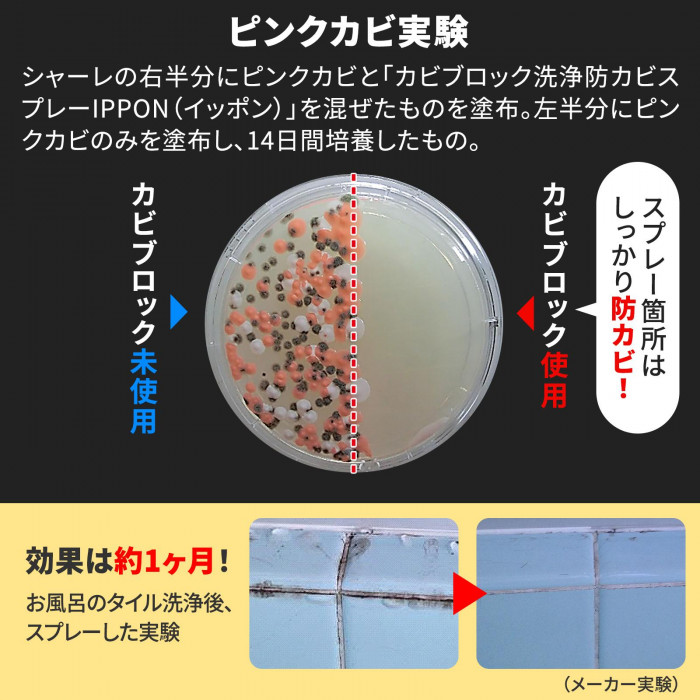
ピンクカビ実験

カビブロック洗浄防カビスプレー IPPON R 200ml 800回分 弱酸性 洗浄 防カビ 消臭 掃除 洗剤 塩素不使用 お風呂 台所 日本製
1,198
\汚れを落として防カビ!/
・塩素や界面活性剤不使用
・家中これ一本でOK◎
・バイオ酵素のチカラでカビを抑制!
・10cm角に1回スプレーで約800回分
【内容量】200ml
【成分】ミネラル水、バイオ酵素剤、乳酸、クエン酸、植物排出物
【製造国】日本
防カビ剤/カーテン/ペット用品/サッシ/風呂場/浴室/畳/壁紙/クローゼット
・塩素や界面活性剤不使用
・家中これ一本でOK◎
・バイオ酵素のチカラでカビを抑制!
・10cm角に1回スプレーで約800回分
【内容量】200ml
【成分】ミネラル水、バイオ酵素剤、乳酸、クエン酸、植物排出物
【製造国】日本
防カビ剤/カーテン/ペット用品/サッシ/風呂場/浴室/畳/壁紙/クローゼット
 |
 |
 |
 |
|
 |
| 塩素や界面活性剤を使わないので、 これ1本で家中どこでも使える洗浄防カビ剤。バイオ酵素の力で、カビの発生を抑制。10cm角に1回スプレーで約800回分。 |
| 商品区分 | 雑貨 |
| 内容量 | 200ml |
| サイズ | 約縦6.5×横5.0×高さ 19.0cm個装サイズ:6.5×5.0×19.0cm |
| 重量 | 約235g個装重量:235g |
| 成分 | ミネラル水、バイオ酵素剤、乳酸、クエン酸、植物抽出物 |
| 生産国 | 日本 |
広告文責
コモライフ株式会社
Tel 06-6345-7927